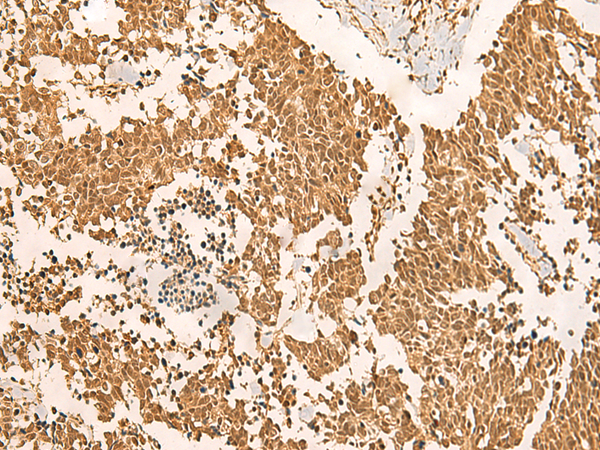

|
Background: |
This gene encodes a GTPase which is a component of the spliceosome complex which processes precursor mRNAs to produce mature mRNAs. Mutations in this gene are associated with mandibulofacial dysostosis with microcephaly. Multiple transcript variants encoding different isoforms have been found for this gene. |
|
Applications: |
ELISA, WB, IHC |
|
Name of antibody: |
EFTUD2 |
|
Immunogen: |
Fusion protein of human EFTUD2 |
|
Full name: |
elongation factor Tu GTP binding domain containing 2 |
|
Synonyms: |
MFDM; MFDGA; Snu114; Snrp116; SNRNP116; U5-116KD |
|
SwissProt: |
Q15029 |
|
ELISA Recommended dilution: |
5000-10000 |
|
IHC positive control: |
Human lung cancer |
|
IHC Recommend dilution: |
50-300 |
|
WB Predicted band size: |
109 kDa |
|
WB Positive control: |
Mouse brain tissue and Jurkat cell lysates |
|
WB Recommended dilution: |
500-2000 |
購(gòu)物車
幫助
021-54845833/15800441009
